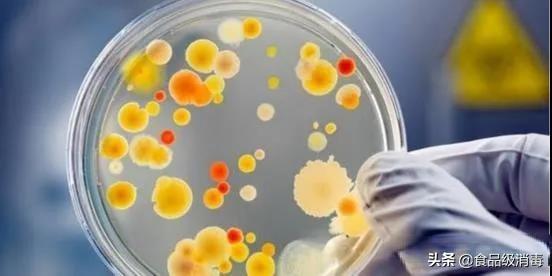
食品厂细菌检测流程,食品菌落总数超标的解决办法

菌落总数通常用来判断食品被微生物细菌污染的程度,菌落总数的多少一般标志着食品卫生质量的好坏。食品菌落总数超标,说明食品致病菌污染几率增加,而这种食品很大几率会危害食用者的身体健康。食品不同的种类有着不同的食品安全认证,菌落总数的限量也根据食物的原材料、生产加工工艺等的不同而有一定的差异。
从卫生角度来说,超过了菌落总数标准,就会被列入卫生不合格产品。如果菌落总数超标严重,可能会造成腹泻。
食品的菌落总数超标的危害:
1、会破坏食物的营养成分
2、加速食品的腐败变质
3、超标严重食用后可使人患上肠道疾病 危害人体健康。
菌落总数并不都是致病菌,菌落总数包括致病菌和有益菌,其中的致病菌,会对人体造成危害,当其进入人体后会破坏肠道里正常的菌落环境,引起腹泻、损伤肝脏等身体器官,菌落总数超标也意味着致病菌超标的机会增大,增加危害人体健康的几率。

食品菌落总数超标的原因
食品菌落总数超标的原因:
1、生产环节,生产加工环节原辅料、人员、设备、环境受到污染和消毒不彻底导致,将细菌带入食品中,导致菌落总数超标。
2、冷却包装环节,在冷却、内包装过程中,遭受空气中细菌二次污染,从而导致食品菌落总数含量超标。
3、运输储存环节, 加工包装后由于运输储存环节消毒和冷藏环节不完善,导致细菌爆发。
食品菌落总数超标问题日益严重,而最主要的源头还是食品生产企业的消毒灭菌不完善导致的,而食品企业在选择灭菌产品时,最关心的莫过于高效灭菌,安全无害,操作简单快捷这些问题。德国奥克泰士的出现大大解决了食品企业的后顾之忧。
德国奥克泰士消毒剂
奥克泰士--德国原装进口,食品级过氧化氢 银离子复合型杀菌消毒剂,奥克泰士拥有强效的广谱杀菌效果,在杀灭病原体细菌、霉菌、酵母菌、大肠杆菌、真菌、病毒生物膜、藻类等物质时效果显著,奥克泰士的功效是经过近200种细菌学,生物学,病毒学和毒物学的测试和验证过的。在食品厂可被用于几乎所有需要达到“灭菌状态”的场合。
▲消毒杀菌能力极强、空间消毒灭菌、表面消毒灭菌效果显著,并且在使用后可以抑制各种微生物、细菌及霉菌的滋生和生长。长期使用,细菌不会产生耐药性。
▲完全环保,完全生物可分解,对人体无任何毒害,应用过程中无腐蚀性,无残留。
▲无色,无气味,无味道,不起沫,完全溶于水,使用安全,从而也保证了食品在生产过程中不会受到影响。
▲广谱杀菌效果,可杀灭有害菌以及有害微生物,在食品生产中,能够杀灭导致食品变质的微生物,保证食品表面不长霉、变质。
▲产品应用简单,无需改变原有的生产工艺,也不需要投入太多的人力、物力以及掌握太多的技术就可以应用。
▲产品来源于德国,达到欧盟的各项要求和安全认证,同时经过国内权威机构的检测,完全符合HACCP的要求,所以使用奥克泰士的客户可以放心出口全球!完全符合国家食品安全法,让你轻松达到国家标准。

德国进口消毒剂—奥克泰士